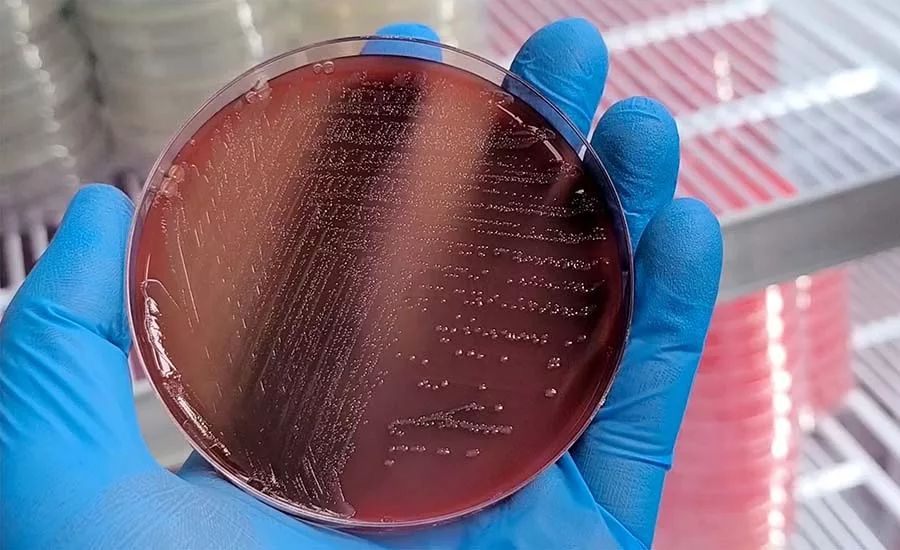
a Petri dish containing a microbial culture medium

Tips for Building Confidence in Your Third-Party Laboratory's Salmonella Results
Salmonella testing plays an important role in reducing risk by providing validation and verification of Salmonella control strategies
Salmonella can cause salmonellosis and is "the leading cause of foodborne illnesses, hospitalizations, and deaths in the United States,"1 according to the Centers for Disease Control and Prevention (CDC). Despite concerted efforts to reduce Salmonella infections, incidences continue to be higher than the targeted rates set by the CDC-driven Healthy People 2030 initiative.2 Recently, the number of domestically acquired foodborne illnesses caused by nontyphoidal Salmonella (i.e., strains that do not cause Typhoid fever), have been estimated to be as high as 1.28 million cases per year,3 resulting in an estimated annual economic burden of $17.1 billion USD.4
Salmonella testing along the farm-to-table continuum plays an important role in reducing Salmonella risks by providing validation and verification of Salmonella control strategies. However, Salmonella testing, especially when following reference methods from the U.S. Food and Drug Administration (FDA) or the U.S. Department of Agriculture's Food Safety and Inspection Service (USDA-FSIS), requires a high level of expertise and can be labor-intensive. Furthermore, results may take over a week to finalize.
In the U.S., FDA regulates approximately 80 percent of the food supply (i.e., all food except for meat, processed eggs, and catfish), meaning that a large proportion of food commodities must adhere to FDA guidelines. Unfortunately, the authors have encountered several testing laboratories that claim to follow the reference methods, specifically FDA's Bacteriological Analytical Manual (BAM) Chapter 5 Salmonella method, but further examination reveals that the methodology is (1) only partly followed, (2) heavily modified without validation, or (3) that "presumptive positives" are labeled as "positives."
In this article, we briefly review why testing for Salmonella is important, the challenges encountered when testing for Salmonella (specifically when using the BAM Chapter 5 guidelines, "Interpretation of presumptive positive results"), and how to evaluate if your testing laboratory is providing reliable testing results.
Why is Salmonella Testing Important?
When Salmonella is a recognized hazard for a commodity (e.g., eggs, spices, produce), a food manufacturer must implement measures to control for this hazard and provide evidence of their effectiveness. Testing raw materials and/or finished products, as well as environmental monitoring programs (EMPs), are common strategies to verify pathogen control. Notably, results from product and EMP testing are typically used to make important business decisions (e.g., release or hold back products, or intensify EMP sampling). It is, therefore, essential that these results are accurate and defendable.
Inaccurate results can come in two forms: false negative and false positive, which both can have severe consequences. False negative results (i.e., samples that are reported to be Salmonella-negative, but are actually positive) can have major public health consequences (e.g., individual salmonellosis cases or outbreaks), as well as business consequences (e.g., recalls). If false negatives are identified after product release, a company may need to initiate a recall, which often carries a huge financial burden and will negatively impact the brand name. On the other hand, false positive results (i.e., samples that are reported to be Salmonella-positive, but are actually negative) will incur unnecessary expenses if raw materials or finished products are discarded or if extensive corrective actions are performed.
Salmonella product and environment testing is a cornerstone of food quality and safety, so it is important to make sure that results are reliable.
Looking for quick answers on food safety topics?
Try Ask FSM, our new smart AI search tool.
Ask FSM →
Why is Salmonella Testing so Challenging?
Salmonella is a diverse genus within the Enterobacteriaceae family that is represented by more than 2,500 serovars,5 including strains with atypical characteristics. While there are multiple options for conducting Salmonella testing, two approaches are often employed: (1) rapid detection via a proprietary screen method (e.g., a commercial PCR method), followed by cultural confirmation of presumptive positives via a reference method, or (2) utilizing the culture-based reference method as a standalone method.
While each approach presents different challenges and advantages, both rely on proper execution of a reference method. Prior to implementation, a rapid method typically requires extensive validation and verification to demonstrate "fit-for-purpose," as well as investments in specialized equipment and proprietary media and reagents. Advantages of these methods include faster time-to-results and simplified workflows. On the other hand, when implementing reference methods, there typically is only a need for general lab equipment and standard media. Culture-based reference methods are accepted as the "gold standard"; therefore, demonstrating "fitness-for-purpose" is typically not necessary. Unlike rapid detection methods, which require minimal baseline knowledge, analysts conducting culture-based reference methods need a strong scientific background with the organism (e.g., Salmonella) and method (e.g., FDA's BAM).
While the commonly used Salmonella reference methods [BAM Chapter 5, USDA MLG 4, and International Standards Organization (ISO) 6579] follow a similar workflow (primary enrichment → selective enrichment → isolation → colony confirmation), there are some key differences. The USDA method is the only reference method to incorporate both rapid detection and rapid identification, which simplify the workflow and expedite results reporting. The ISO method is the only method to include isolation onto chromogenic agar, which allows for improved differentiation of Salmonella from "Salmonella-like" Enterobacteriaceae, compared to the traditional agars used by FDA and USDA. While there is a preference in the U.S. to use U.S. reference methods, the ISO standard is globally recognized and validated by multiple countries. Among these reference methods, BAM Chapter 5 has the most complex workflow and the longest time-to-results: 4 days for a negative result and 5–7 days for a confirmed positive result.
How are Salmonella-Presumptive Positive Results Interpreted?
Given that laboratory results can drive business decisions, it is important that food manufacturers understand how to interpret these results and communicate them clearly. Briefly, Salmonella results have three classifications: (1) presumptive positive, (2) confirmed positive, and (3) negative.6,7 A presumptive positive is a preliminary indication of the potential that a sample may be Salmonella-positive. However, the probability that a presumptive positive is a true positive is dependent on the testing method (rapid screen or culture only) and appearance (atypical or typical) of the result.
In the absence of a rapid screen, a presumptive positive determination is based on colony morphology; certain morphologies are less likely to be Salmonella. Notably, most traditional agars (i.e., non-chromogenic) have limited selective and differential capability; non-Salmonella Enterobacteriaceae and atypical Salmonella are indistinguishable on FDA and USDA-specified agar plates.8 Conversely, a presumptive positive generated by a rapid screen method (especially a molecular-based test) typically has a high probability of being confirmed as Salmonella-positive, as non-Salmonella should not be detected.
While it is acceptable to treat a presumptive positive as a confirmed positive result (i.e., destroy food products or perform EMP corrective actions), it is critical to understand that the sample may be Salmonella-negative and have a rough understanding of the likelihood that a presumptive positive with a given test may actually represent a negative sample. Regardless of the origin (rapid or cultural), misclassifying a presumptive positive as a confirmed positive is misleading and should be avoided.
How to Assess Your Testing Laboratory
Based on the consequences that invalid test results can have and the complexity of Salmonella testing, it is important to be able to assess whether a testing laboratory provides reliable and accurate Salmonella results. Here, we outline three key considerations for measuring a laboratory's ability to produce high-quality data.
Consideration 1: The Laboratory's Scope of Accreditation
A starting point for evaluating a testing laboratory is whether the laboratory is certified or accredited. ISO/IEC 17025 is a globally recognized standard that defines criteria (e.g., training and calibration documentation, full traceability to all test activities) to prove laboratory competence. To be an ISO/IEC 17025-certified laboratory, an organization must be accredited through a third-party accreditation body.9 An accreditation certificate will contain a "Scope of Accreditation" that lists which test methods the laboratory is accredited to use. Methods listed on a laboratory's scope are subject to a higher level of scrutiny (i.e., annual audits, proficiency tests) than are methods not listed on the scope. If the testing laboratory lists FDA BAM Chapter 5, ISO 6579, or FSIS/USDA MLG4 on its scope of accreditation, then the laboratory must follow those procedures as written. Any modifications must be validated and reflected on the laboratory's scope, as well as on the certificate of analysis (COA).
Similarly, if the laboratory offers alternative Salmonella testing methods, such as rapid detection methods validated through third-party standards organizations (e.g., AOAC INTERNATIONAL), these too should appear on the laboratory's scope. Laboratory-developed methods are also acceptable if appropriately validated; however, food manufacturers should review the validation data to ensure that method performance has been properly assessed. No matter which testing method is listed, it is important to check if the method is appropriate for the matrix that is being tested (e.g., a testing method validated for meat products should not be used on dairy products without prior validation).
In the context of Salmonella identification and/or testing, testing laboratories can also be accredited by FSIS and/or FDA. FSIS has its own Accredited Laboratory Program (ALP) to accredit laboratories to test products regulated by USDA for the presence of Salmonella and to perform serotyping of Salmonella.10 FDA recognizes accreditation bodies that accredit laboratories as Laboratory Accreditation for Analyses of Foods Program (LAAF) laboratories, meaning they can conduct food testing with specified testing methods (i.e., laboratory scopes).11 Testing laboratories that are either accredited as ALP or LAAF laboratories need to follow both ISO/IEC 17025 standards and additional requirements set forth by FSIS or FDA, respectively.
Consideration 2: The Testing Laboratory's Local Procedures
After reviewing the laboratory's level of accreditation, it is essential to compare the laboratory's written procedure against the method listed on the scope. The Salmonella culture-based methods, like other reference methods, outline optional testing pathways; it is important to know which pathway is selected and whether any have been eliminated. For example, the FDA method allows for a molecular screen prior to cultural isolation, but this is not required. As discussed above, a presumptive positive generated by a molecular method has a much higher probability of being Salmonella-positive compared to those reported from colony morphology alone. However, alternative rapid screen methods can be applied only to the matrices and analytical weight (e.g., 25 grams) claimed by the developer of the method; modifications to the claim require proof that the method is "fit-for-purpose."
Additional validation or verification data to support testing new matrices or higher analytical weights should be readily available to the laboratory's customers. Local procedures should be sufficiently detailed, easy to follow, and not reliant on word-of-mouth or institutional knowledge. Training documentation should be available for all analysts, and a training program should be defined in a Standard Operating Procedure (SOP).
When using a testing laboratory that reports only "presumptive positive," we recommend determining if the laboratory has the capability to further assess a presumptive positive (i.e., cultural confirmation through collaboration with another laboratory) to get clarity on how to proceed and prevent extensive expenses if the presumptive positives cannot be confirmed as positive. If presumptive positives are outsourced for confirmation, the laboratory should have an SOP for this, as well. Key considerations for outsourcing include:
- Shipping and receiving hazardous material capability
- Confirmation methodology
- Expected time-to-results.
When a testing laboratory reports only "presumptive positive," we also recommend a review to assess the likely frequency of presumptive positives from Salmonella-negative samples; this may require securing help from outside experts.
Consideration 3: Positive and Negative Process Control Samples
After reviewing the accreditation scope and the laboratory-specific method, it is important to review the laboratory's process control procedures. Control sample data provide key insights into the ongoing risk for false positives (e.g., through laboratory contamination) and false negatives. The ISO/IEC 17025 standard defines requirements for incorporating control samples, but how the requirements (e.g., frequency, contamination level) are met are left to the laboratory's discretion. For guidance, the reference methods provide recommendations for positive and negative controls, but a laboratory may not necessarily adopt these controls.
The FDA and USDA reference methods list recommendations for genetically modified and atypical strains, as well as negative controls. Genetically modified strains allow for a quick assessment of laboratory contamination, as these are easily differentiated from naturally occurring strains. Atypical strains provide a benchmark for recognizing less common Salmonella morphologies. To ensure the method is performed correctly, positive controls should be inoculated at low levels, ideally into a food matrix or environmental sample, and all controls should be run concurrently with customer samples.
For continued evaluation of laboratory performance, the order that samples and controls are processed also matters: customer samples should be processed first, followed by positive control(s), followed by negative control(s). The uninoculated control should be processed last. This strategic order prevents cross-contamination of customer samples by the positive control, while allowing for continuous monitoring of proper technique—e.g., how frequently is the negative control contaminated by the positive control?
Conclusion
Monitoring for Salmonella throughout the food chain is important to ensure that food released into commerce is safe. As reviewed here, confirming the presence or absence of Salmonella can be a lengthy, complex process that is prone to error and misinterpretation if not properly managed. While accrediting bodies provide some oversight, the burden of generating accurate and reliable results lies primarily with laboratory management. As with food production facilities, laboratories need to implement robust systems that are fully traceable and continuously monitored.
The relationship with your testing laboratory is important. To instill confidence, testing labs should be transparent and accommodating of requests for information. Additionally, food manufacturers should have the required expertise (either in-house or contracted) to assess Salmonella laboratory methods, review testing methods and labs used, and set clear and high expectations for their testing labs. This will prevent worst-case scenarios where labs may use and implement methods incorrectly (leading to inaccurate results, such as a large number of presumptive positives that are not Salmonella) or where a Salmonella presumptive positive is colloquially communicated as a "Salmonella hit."
Resources
Publicly available Salmonella spp. reference methods include:
- FDA BAM Chapter 5: Salmonella: https://www.fda.gov/media/178914/download?attachment
- FDA Salmonella Flipbook (guide to identify Salmonella on media and slants used in FDA BAM Chapter 5): https://fda.report/media/99528/Salmonella-Flipbook.pdf
- FSIS/USDA MLG4: Isolation and Identification of Salmonella from Meat, Poultry, Pasteurized Egg, Siluriformes (Fish) Products, and Carcass and Environmental Sponges: https://www.fsis.usda.gov/sites/default/files/media_file/documents/MLG_4.15.pdf
- American Association for Laboratory Accreditation (A2LA) directory of ISO 17025:2017-accredited laboratories: https://customer.a2la.org/index.cfm?event=directory.index
- FDA LAAF-accredited laboratories (includes all accreditation bodies recognized by FDA, all LAAF-accredited laboratories, and all accreditation scopes): https://datadashboard.fda.gov/oii/fd/laaf.htm
- FSIS-accredited laboratories: https://www.fsis.usda.gov/sites/default/files/media_file/2022-05/Current-ALP-Lab-List.pdf
References
- Centers for Disease Control and Prevention (CDC). "About Salmonella Infection." October 4, 2024. https://www.cdc.gov/salmonella/about/index.html.
- CDC. "FoodNet 2023 Preliminary Data." September 4, 2024. https://www.cdc.gov/foodnet/reports/preliminary-data.html.
- Walter, E.J.S., Z. Cui, R. Tierney, et al. "Foodborne Illness Acquired in the United States—Major Pathogens, 2019." Emerging Infectious Diseases 31, no. 4 (April 2025), 669–677. https://wwwnc.cdc.gov/eid/article/31/4/24-0913_article.
- Hoffmann, S., A.E. White, R.B. McQueen, et al. "Economic Burden of Foodborne Illnesses Acquired in the United States." Foodborne Pathogens and Disease 22, no. 1 (January 2025): 4–14. https://pubmed.ncbi.nlm.nih.gov/39354849/.
- Grimont, P.A.D. and F.X. Weill. (2007). Antigenic formulae of the Salmonella serovars. 9th Ed. WHO Collaborating Centre for Reference and Research on Salmonella and Institut Pasteur. https://www.scacm.org/free/Antigenic%20Formulae%20of%20the%20Salmonella%20Serovars%202007%209th%20edition.pdf.
- U.S. Food and Drug Administration (FDA). "Chapter 5: Salmonella." Bacteriological Analytical Manual (BAM). May 2024. https://www.fda.gov/media/178914/download.
- FDA. Guidance for Industry: Testing for Salmonella Species in Human Foods and Direct-Human-Contact Animal Foods. March 2012. https://www.fda.gov/media/83177/download.
- Forstner, M.J. "Salmonella Flipbook." Minnesota Department of Agriculture Laboratory Services. https://fda.report/media/99528/Salmonella-Flipbook.pdf.
- International Organization for Standardization (ISO). "ISO/IEC 17025: Testing and Calibration Laboratories." 2020. https://www.iso.org/ISO-IEC-17025-testing-and-calibration-laboratories.html.
- U.S. Department of Agriculture Food Safety and Inspection Service (USDA-FSIS). "Accredited Laboratory Program." 2026. https://www.fsis.usda.gov/science-data/laboratories-procedures/accredited-laboratory-program.
- FDA. (2022). Laboratory Accreditation for Analyses of Foods (LAAF) Program & Final Rule. Current as of August 12, 2024. https://www.fda.gov/food/food-safety-modernization-act-fsma/laboratory-accreditation-analyses-foods-laaf-program-final-rule.








